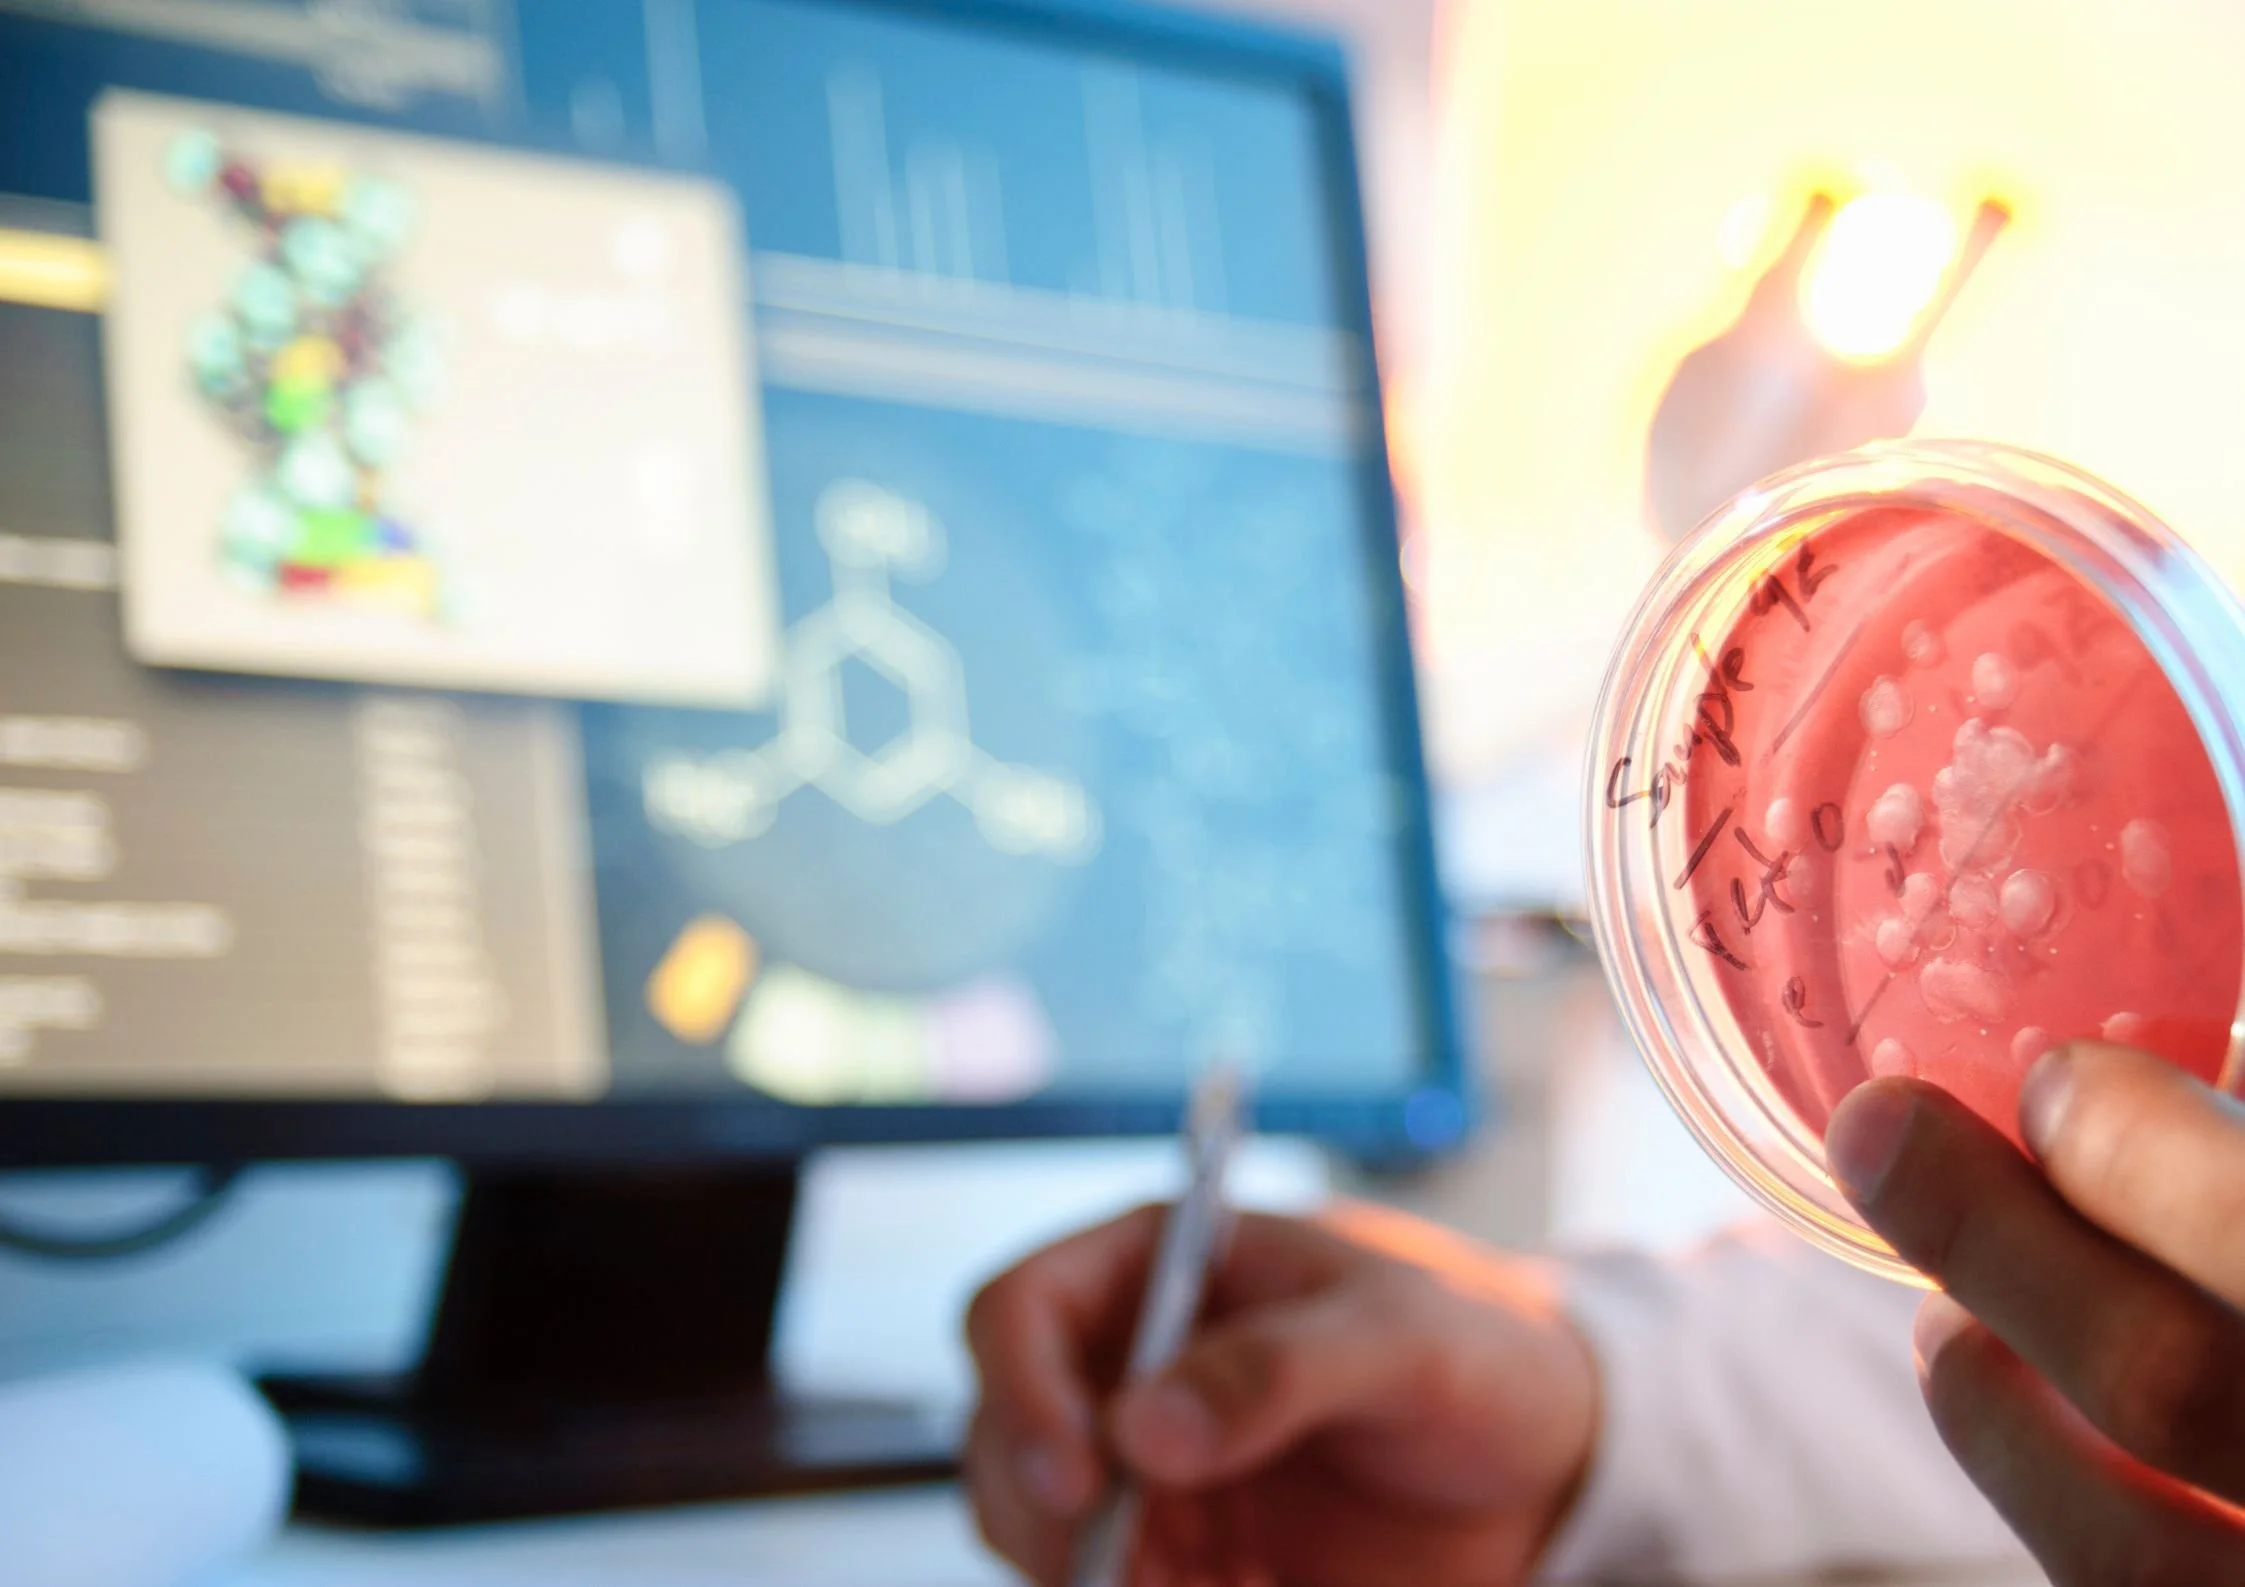

University of Florida offers microbiology boot camps, bringing online STEM lessons to life
The University of Florida says its microbiology boot camps are a “game changer” for its online students, bringing microbiology to life.
Despite the popularity of online learning, a recent study found that STEM students are less satisfied with the digital learning experience.
University of Florida Online aims to change this with its new approach that combines dynamic online STEM courses with in-person lab experiences.
“It was the first time I had a chance to apply all the things I’d been learning [online],” explains Emma Ward, a student who participated in a Summer 2025 boot camp while completing her bachelor’s degree in microbiology and cell science at University of Florida Online. “It gave me a deeper understanding that I couldn’t have gotten just from reading or watching videos.”
After completing online quizzes and learning modules, students spend five days in the laboratory before completing the program with reflection and data analysis.
“Microbiology is a STEM discipline; it’s meant to be touched, observed and experimented with,” explains Monika Oli, PhD, a University of Florida Master Lecturer and Teaching Professor. “We wanted to make sure our online students received the same quality education and lab training as our on-campus students.”
“Whether it’s food microbiology, or understanding water safety, the lab plants seeds for lifelong curiosity,” adds Oli. “On day one, students may be hesitant, but by day five, they’re confident, working independently and proud of what they’ve accomplished.”
After successfully boot camps in microbiology, the Department of Chemistry and University of Florida Online plan to launch an organic chemistry lab in summer 2026.
The ETIH Innovation Awards 2026
The EdTech Innovation Hub Awards celebrate excellence in global education technology, with a particular focus on workforce development, AI integration, and innovative learning solutions across all stages of education.
Now open for entries, the ETIH Innovation Awards 2026 recognize the companies, platforms, and individuals driving transformation in the sector, from AI-driven assessment tools and personalized learning systems, to upskilling solutions and digital platforms that connect learners with real-world outcomes.
Submissions are open to organizations across the UK, the Americas, and internationally. Entries should highlight measurable impact, whether in K–12 classrooms, higher education institutions, or lifelong learning settings.
Winners will be announced on 14 January 2026 as part of an online showcase featuring expert commentary on emerging trends and standout innovation. All winners and finalists will also be featured in our first print magazine, to be distributed at BETT 2026.